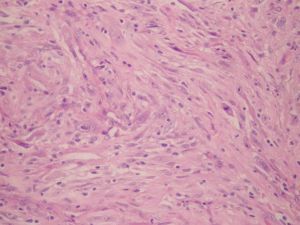
外陰神經鞘瘤

外陰神經鞘瘤是由什麼原因引起的?
(一)發病原因
目前一般認為外陰神經鞘瘤是來源於外胚層的施萬細胞(schwann cell)。以往有人認為其來源於中胚層神經鞘。
外陰神經鞘瘤
外陰神經鞘瘤(二)發病機制
外陰神經鞘瘤為孤立生長緩慢的良性腫瘤,多呈圓形,直徑為4cm大小,少數可達10cm,腫瘤可有完整的包膜切面實性,白色韌帶,常見淡黃色斑區,可伴少數囊腔,含淡黃色液體,也有以囊性為主者。腫瘤表面血管豐富,有完整的包膜。
鏡下見包膜內有許多小血管,部分腫瘤細胞排列紊亂,結締組織呈細網狀,並可見組織變性而形成的小囊腫,囊腔內充滿液體。另一部分腫瘤細胞排列較密集、核長,梭形成柵欄狀排列,同時與無核區域相同。腫瘤的另一特點是在許多血管周圍有一層厚的膠原纖維鞘。
外陰神經鞘瘤有哪些表現及如何診斷?
外陰神經鞘瘤常見於四肢及陰部,通常表現為圓形的皮下結節,為單發、也可多發。呈大小不等柔軟、散在的腫塊,一般無自覺症狀,有時伴有疼痛和壓痛。
根據臨床上有陣發性疼痛的特點及實驗室相關檢查,可進行初步的診斷。但仍需要取活體組織行病理檢查進行確診。
外陰神經鞘瘤應該做哪些檢查?
免疫組化檢查、腫瘤標誌物檢查。
組織病理檢查。
外陰神經鞘瘤容易與哪些疾病混淆?
主要與平滑肌瘤鑑別,前者指神經鞘瘤常有波浪核狀,胞質淡染色,如細絲狀,後者核鈍圓,胞質紅染,免疫組化染色,前者S-100和NSE陽性,後者SMA陽性。
外陰神經鞘瘤可以並發哪些疾病?
伴發神經纖維瘤。
外陰神經鞘瘤吃什麼好?
外陰神經鞘瘤吃那些對身體好?
(1)宜多吃具有抗外陰腫瘤的食物,如芝麻、杏仁、小麥、大麥、土瓜、烏骨雞、烏賊、烏梢蛇、豬胰、菊花、烏梅、桃子、荔枝、馬齒莧、雞血、鰻魚、鮑魚、蟹、鱟、沙丁魚、文蛤、玳瑁。
(2)疼痛宜吃鱟、赤、龍蝦、淡菜、海參、虎魚、甜菜、綠豆、蘿蔔、雞血。
(3)瘙癢宜吃莧菜、白菜、芥菜、芋艿、海帶、紫菜、雞血、蛇肉、穿山甲。
(4)增強體質、預防轉移宜吃銀耳、黑木耳、香菇、猴頭菇、雞肫、海參、薏米、核桃、蟹、石龍子、針魚。
(5)外陰神經鞘瘤手術手術後,耗氣傷血,宜多食補氣養血之品,如大棗、龍眼、扁豆、粳米、荔枝、香菇、胡蘿蔔、鵪鶉蛋、藕粉、豆類等。
(6)外陰神經鞘瘤手術後的放療:耗陰損液,宜多食滋陰養液之品,如菠菜、小百菜、藕、犁、西瓜、香蕉、葡萄、海參、甘蔗、百合等。
(7)外陰神經鞘瘤手術後的化療:易氣血兩損,宜常食補養氣血之物,如木耳、香菇、核桃仁、桑椹、苡米粥、紅棗、桂圓、海參等。
外陰神經鞘瘤最好不要吃那些食物?
1.禁食發物。如魚類、蝦、蟹、雞頭、豬頭肉、鵝肉、雞翅、雞爪等,食後會加重陰部的瘙癢和炎症。
2.儘量少吃辛辣、刺激的食物。例如:洋蔥、胡椒、辣椒、花椒、芥菜、茴香。
3.避免吃油炸、油膩的食物。如油條、奶油、黃油、朱古力等,這些食物有助濕增熱的作用,會增加白帶的分泌量,不利於病情的治療。
4.戒菸戒酒、咖啡等興奮性飲料。
抗腫瘤食物分類:
1、軟堅類食品 海產品中的海蜇、海帶、紫菜、淡菜、海參、鮑魚等。河產品中蓴紫,也能軟堅。甲魚、烏龜,也有軟堅作用,還有一定清熱作用和滋陰作用。
2、活血類食品 中醫認為,不少腫瘤可表現為血瘀。治療採用活血化瘀藥。蟹能解結散血,對於有血瘀的癌腫,甚為適合。蟹爪、蟹殼也有破血功能。山楂可以幫助消化,也有活血作用。
3、理氣類食品 如橘皮、金橘、佛手、檸檬皮等。
4、消導類食品 蘿蔔能消食化痰,腹脹時也適宜食用。生薑可開胃,還可止吐。山楂也可消肉食。
5、清熱類食品 綠豆,清熱解毒,有癌性發熱時可食用。絲瓜,涼血解毒。
6、健脾類食品 米仁,具有健脾益胃補肺的功能。且能破毒腫、治肺瘺、肺氣積膿血等。赤豆,健脾利濕,脾虛有水腫時,可食。鯽魚,健脾益氣,在腹水時也可食用。
7、壯陽類食品 羊肉,溫補元氣,但陰虛、熱證時忌食。鰻魚,溫補。雞,是大補元氣的食品,但性溫、熱證、陰虛時當忌。
8、滋陰類食品 生梨,生津潤肺。甘蔗汁,生津養陰,且能止吐。蜂蜜,滋陰潤燥。西瓜,生津清熱。鴨,滋陰,但性滋膩難消化。豬肉皮,也有滋陰作用。
9、其他有益的食品 如各種蕈類,對各種腫瘤病人都可吃。大蒜,防癌可能有益。蘆筍、彌猴桃等也有益。
外陰神經鞘瘤應該如何預防?
1.早發現、早診斷、早手術治療,做好隨訪工作。
2. 預後:
與腫塊預後明顯相關的因素:腫塊的大小、根治性手術切除的完整性、是否合併神經纖維
瘤病和核分裂數等因素。
外陰神經鞘瘤西醫治療方法
1.手術 早期患者手術為首選,根據發病部位根治性外陰切除術、一側外陰切除術、根治性陰蒂切除術或前盆腔除髒術。如婦檢或影像學提示淋巴結有轉移可能,可行淋巴結取樣活檢,常規淋巴結切除並不推崇,因為該瘤大多為血行傳播。
2.放療 Lambrou等(2002)因外陰腫塊巨大無法根治性切除,所以在術前予以外照射,腫塊縮小了約50%,但放療的作用尚不確切,尤其對於合併有神經纖維瘤病的患者需慎用,因為會增加繼發腫瘤的可能。
3.化療 對於不能手術切除或不能徹底切除獲根治者,可給以化療。化療對轉移病灶的效果優於局部復發病灶,常用的化療方案有VAC(長春新鹼、放線菌素D和環磷醯胺)、多柔比星(阿黴素)和異環磷醯胺。但有學者認為單用多柔比星(阿黴素)和多柔比星(阿黴素)與其他藥物聯合套用後的總生存率和疾病緩解生存率並無差異。Lambrou等建議對腫塊>5cm、位於深部組織、高度惡性等有復發高危因素的患者予以術後多柔比星(阿黴素)治療。
醫學疾病任務——婦科
| 婦科是醫療機構的一個診療科目,是婦產科的一個分支專業,是以診療女性婦科病為診療的專業科室。女性生殖系統所患的疾病才叫婦科疾病。婦科疾病的種類可分很多種,本任務包含大多數婦科疾病。 |

